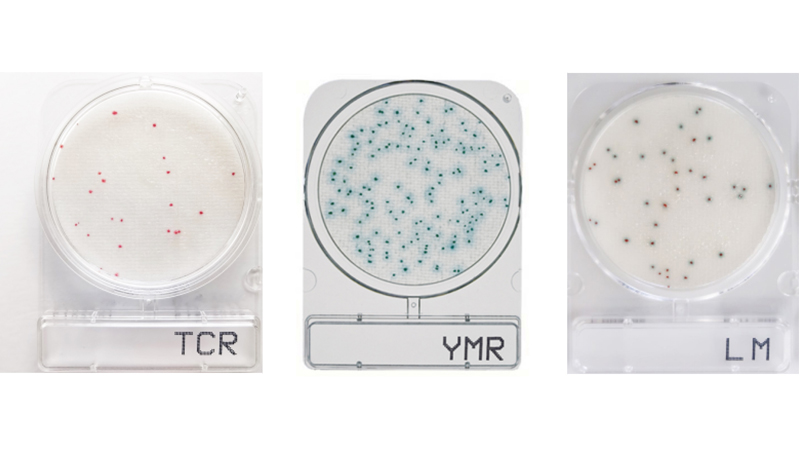
产品三.jpg

作为食品安全技术领域规模最大、人气最旺和最受欢迎的行业盛会之一,CBIFS第十八届食品安全技术论坛暨太平洋食安展将于2026年4月9日-10日在苏州举办。
优尼赛斯确认参展本次论坛,欢迎各位领导专家和客户朋友参观交流、合作洽谈!

北京优尼赛斯科技有限公司
北京优尼赛斯科技有限公司成立于2008年,专注于食品安全检测领域,以为广大食品生产和加工企业、政府实验室、第三方检测机构以及大专院校、科研单位提供专业产品和优质服务为经营宗旨。
我司致力于引进国内外食品安全相关的新技术、新方法、新产品,是多家国际知名企业的合作伙伴。长期以来,我们的团队为各类食品检测机构提供优质产品及全方位技术服务,在业内享有良好的信誉,为广大客户所信赖。
我司在大中华区独家代理比利时Unisensor公司药物残留快速检测系列产品,同时还是生物梅里埃(法国)、帝斯曼(荷兰)、Hygiena(美国)、Kikkoman(日本)、Shimadzu(日本)等知名企业的授权代理商,在微生物、理化、实验室自动化等方面提供全面的仪器设备、配套耗材及技术解决方案。
电话:01059396775
地址:北京市朝阳区朝阳北路11 号首开东都汇B座511
网址:www.uni-science.cn

- 扫码关注公众号 -

手持式ATP荧光检测仪
• 超高灵敏度,可检测ATP+ADP+AMP
• 10秒快速得到结果
• 食品安全风险控制的得力助手,优化过程控制的必备工具
运用ATP荧光检测(A3法)可确认食品加工现场中各种潜在的风险,以便尽早发现 问题、解决问题,力争实现零食物中毒事故!

EasyPlate微生物测试片
• 即开即用,无需制备培养基,高效省时接种方便
• 易于计数,结果可靠
• 节省培养空间
• AOAC等权威认证
即开即用的微生物测试片培养基, 可节省操作时间和减少使用后弃置量,简化检测流程,广泛应用于微生物检测环节。
CompactDry微生物测试片
• 缩短检验人员劳动时间,节约水电以及清洁等成本;
• 减少人员操作误差,保证检测结果可靠,与传统平板培养法具有良好的统一性;
• 通过AOAC等国际认证;
• 缩短检测时间,加快货物流转速度,节约仓储成本;
• 检测更多的微生物种类,提升实验室检测能力。
即开即用的微生物测试片培养基, 可节省操作时间和减少使用后弃置量,简化检测流程,广泛应用于微生物检测环节。

环境涂抹产品
• 采样时无需人手接触,便于擦拭排水口、管道和设备周围的区域
• 可配合国标培养基或微生物测试片使用
• 恢复受损微生物细胞,提高检出率,使结果更真实可靠
应用于食品、饮料、制药等行业的表面采样程序

黄曲霉毒素M1/B1检测试剂盒
• 快速、高灵敏度检测试剂盒;
• 30-90分钟即可出结果;
• 操作简便,易于使用;
• 良好的产品稳定性和结果重现性。
用于饲料、谷物、坚果和谷物等产品中的黄曲霉毒素M1/B1的定量检测。




